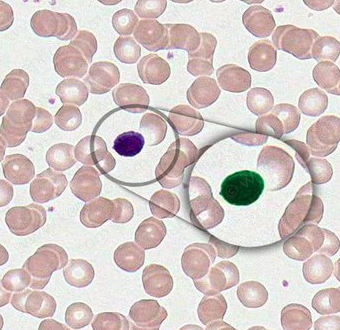
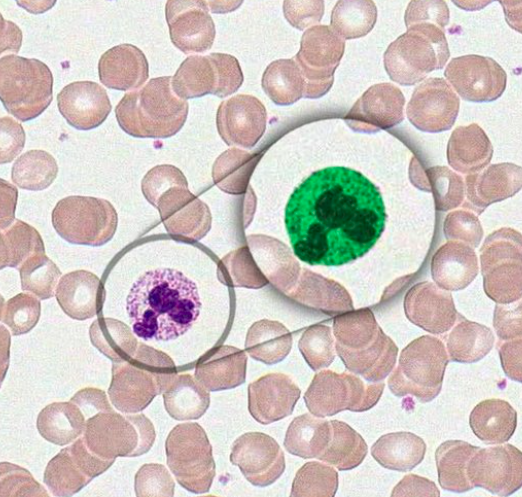
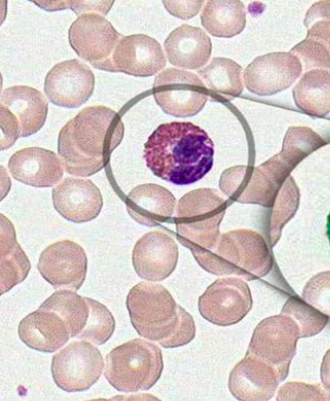
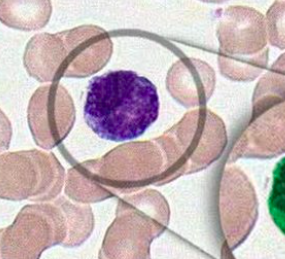

Los leucocitos se dividen en:
- Agranulocitos: monocitos y linfocitos
- Granulocitos: neutrófilos, eosinófilos y basófilos
Cómo se ven los monocitos:
Núcleo en “pompi”

Cómo se ven los linfocitos?
Núcleo perfecto
Cómo se ven los neutrófilos?
Polimorfonucleares
Huellitas
Cómo se ven los eósinofilos?
Hay gránulos naranjas-rosas en citoplasma:
Cómo se ven los basófilos?
Tienen muchos gránulos muy azules
Tinción para sangre
De Wright
Para qué sirven los eosinófilos?
- Asocian a reacciones alérgicas
- Infestaciones parásitos
- Activados por inmunoglobulinas
Litros de sangre en un adulto
Entre 4.5 y 6 L
Proteína más abundante y sus funciones:
Albúmina
Se produce en hígado, se encuentra en el plasma, mantiene la presión coloidosmótica
Proteína más grande en sangre:
Fibrinógeno
¿Qué contiene el suero?
Proteínas pero sin fibrinógeno, sin factores de coagulación
Granulocitos

Vida de un eritrocito
120 días
Quién fija la hemoglobina?
Proteína banda 3
Quién le da forma al eritrocito?
Espectrina
alpha y beta
1ra línea de defensa, leucocito más abundante:
Neutrófilo
Dónde ocurre la hematopoyesis?
En médula ósea
Qué célula se puede diferenciar a c. plasmática
No necesariamente lo hace
Linfocito B
Estudio para ver morfología de las células
Aspirado de médula ósea
Pancitopenia:
disminución en células sanguíneas
¿cómo se difencían visualmente (lab) los tipos de linfocitos?
Por inmunohistoquímica
Marcadores para linfocitos B
CD19
CD20
CD24
Marcadores para linfocitos NK
CD56



